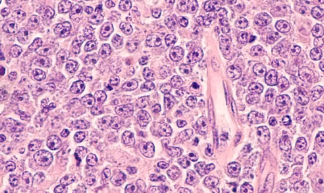

림프종 초기증상 총정리: 조기 발견을 위한 주요 신호
- 건강에 대한 흥미로운 정보들
- 2025. 3. 22. 16:45
림프종 초기증상 총정리: 조기 발견을 위한 주요 신호
**림프종(Lymphoma)**은 림프계에 생기는 혈액암의 일종으로, 면역세포인 림프구가 비정상적으로 증식하며 발생합니다.
일반적인 암과 달리 다양한 부위에서 발생할 수 있고, 감기와 비슷한 증상으로 시작되기 때문에 조기 발견이 어렵습니다.
그러나 조기에 치료하면 완치율이 높은 암이기도 하므로, 초기 증상에 대한 인식이 매우 중요합니다.
이번 글에서는 림프종의 대표적인 초기증상, 종류에 따른 차이, 감별해야 할 다른 질환, 진단 방법까지 자세히 안내드립니다.
1. 림프종의 대표 초기증상

증상 특징
| 무통성 림프절 종대 | 목, 겨드랑이, 사타구니 등 림프절이 딱딱하게 붓고 아프지 않음 |
| 만성적인 피로감 | 충분히 쉬어도 피로가 지속, 전신 무기력 |
| 야간 발한 | 자다가 옷이 젖을 정도로 땀을 흘림, 불쾌감 동반 |
| 원인 없는 체중 감소 | 식사량 변화 없이 6개월 내 체중 10% 이상 감소 |
| 열(미열~고열 반복) | 이유 없이 자주 열이 나고 감기 증상 없음 |
| 가려움증 | 피부에 발진이 없는데도 전신이 심하게 가려움 |
📌 림프절이 부었는데 통증이 없고, 2주 이상 지속된다면 반드시 병원 진료가 필요합니다.
2. 림프종 종류에 따른 초기 차이점



종류 주요 증상 특징
| 호지킨 림프종 | 목 림프절 붓기, 야간 발한, 체중 감소 | 주로 20~30대 젊은 층에서 발생, 예후 양호 |
| 비호지킨 림프종 | 다양한 림프절, 복부, 장기 침범 가능 | 전 연령층에서 발생, 다양한 아형 존재 |
| 말초 T세포 림프종 | 피부 가려움, 피부 발진 | 진행이 빠르고 예후가 나쁜 편 |
| 버킷 림프종 | 복부 팽만, 턱 주변 덩어리 | 소아·청소년에서 흔함, 빠른 진행 |
3. 림프종과 감별이 필요한 질환들



구분 림프종 감기/감염 결핵
| 림프절 붓기 | 단단하고 무통성, 지속됨 | 통증 있고, 며칠 내 호전 | 단단하며 미열 동반, 오래 지속됨 |
| 발열 패턴 | 미열~고열 반복, 야간 발한 | 고열 후 빠르게 회복 | 간헐적 발열 |
| 피로감 | 심하고 장기적 | 단기적, 휴식 후 회복 | 장기 지속 |
| 체중 변화 | 급격한 감소 | 거의 없음 | 체중 감소 있음 |
📌 림프종은 감기처럼 보이지만 지속 시간, 통증 유무, 체중 변화 여부로 감별이 가능합니다.
4. 림프종 의심 시 받는 검사



✅ 혈액검사 – 염증수치, 백혈구, 간·신장 기능, LDH 수치
✅ 조직검사 – 림프절을 떼어내 정밀 조직검사 (가장 중요한 진단법)
✅ CT/MRI/PET-CT – 병의 위치와 전이 여부 확인
✅ 골수검사 – 림프종이 골수까지 침범했는지 확인
✅ 면역표현형 검사 – B세포성인지 T세포성인지 구분
5. 조기 진단이 중요한 이유



- 초기 림프종은 항암치료 및 방사선 치료 반응이 매우 좋음
- 호지킨 림프종의 경우 5년 생존율 85% 이상
- 무증상이라도 림프절이 2주 이상 붓거나 통증 없을 경우 반드시 병원 내원 필요
- 진행된 경우에는 항암제 내성, 전신 증상 악화 등으로 치료가 어려워질 수 있음
✅ 결론: 림프종은 감기와 비슷하지만 훨씬 더 조용하고 오래가는 질병입니다
✔ 목, 겨드랑이, 사타구니 림프절이 딱딱하고 아프지 않으며 2주 이상 지속되면 병원 진료 필수
✔ 발열, 체중 감소, 식은땀, 피로감은 암의 대표적 경고 신호
✔ 감염과 감별이 어렵다면 조직검사 및 영상진단이 필요
✔ 조기 진단 시 치료 성공률 높고 완치도 가능
✔ 정기적인 건강검진, 만성 피로 증상 체크로 예방 가능
📌 “몸의 붓기와 피로가 계속된다면, 단순 감기가 아닌 림프종의 신호일 수 있습니다. 빠르게 진료받아보세요.”
'건강에 대한 흥미로운 정보들' 카테고리의 다른 글
| 급성 골수성 백혈병(AML) 증상 총정리: 조기 발견이 생명을 좌우합니다 (0) | 2025.03.22 |
|---|---|
| 혈액순환이 안되면 나타나는 증상 총정리: 우리 몸이 보내는 경고 신호 (0) | 2025.03.22 |
| 혈청 크레아티닌 정상 수치 총정리: 성별·연령별 기준과 의미 (0) | 2025.03.22 |
| 십이지장 궤양 증상 총정리: 놓치기 쉬운 초기 신호부터 경고 증상까지 (0) | 2025.03.22 |
| 밤에 소변이 자주 마려운 증상: 야간뇨의 원인과 해결법 총정리 (1) | 2025.03.21 |